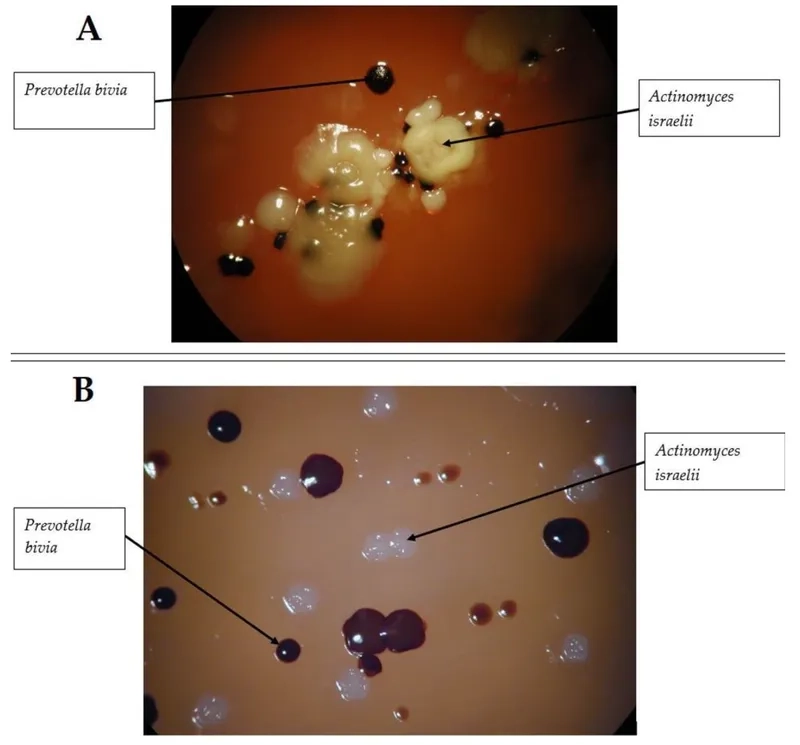
Explaining how Acinetobacter is transmitted in hospitals

Don't overlook the signs of a rare bacterial infection. Understanding Actinomycosis is the first step toward proper diagnosis and effective treatment. This guide provides the essential facts you need to know about this uncommon but serious condition, empowering you to seek timely care.
What are the main causes of Actinomycosis?
- What is Actinomycosis? It is an infection caused by anaerobic bacteria, most commonly Actinomyces israelii, which normally live harmlessly in the mouth and gut.
- The infection begins when these bacteria breach mucosal barriers due to trauma, often following a dental abscess, tooth extraction, or poor oral hygiene.
- Pelvic actinomycosis is a rare form that can affect women, sometimes linked to tissue injury from the long-term use of an intrauterine device (actinomycosis IUD).

Key symptoms of Actinomycosis to watch for
- The most classic of actinomycosis symptoms is a slow-growing, hard, reddish lump on the face or neck, often called "lumpy jaw," which can drain pus.
- Draining abscesses may contain visible yellowish specks known as "sulfur granules," which are characteristic clumps of the bacteria, not actual sulfur.
- Thoracic actinomycosis can cause chest pain and fever, while abdominal infections may lead to pain, fever, or a palpable mass in the abdomen.
How can you prevent Actinomycosis effectively?
- The best prevention method is maintaining excellent oral hygiene, including regular professional dental check-ups to prevent infections that can trigger the disease.
- Seek prompt medical care for any injuries or infections, especially in the mouth, jaw, neck, and pelvic regions, to prevent bacterial spread.
- The condition is not contagious, so prevention focuses entirely on individual health and hygiene rather than avoiding contact with infected persons.
>>> See more: Murray valley encephalitis - A serious mosquito-borne disease in Australia
Images visual examples of Actinomycosis

>>> Learn now: The plague - History, symptoms, and modern treatment
Proper diagnosis of actinomycosis is crucial for recovery. The standard actinomycosis treatment is a long course of high-dose antibiotics, most often penicillin. If you notice any persistent lumps or non-healing sores, see a doctor immediately for evaluation and to ensure the best outcome.
>>> Don't miss: Rocky mountain spotted fever - Recognizing the life-threatening rash






